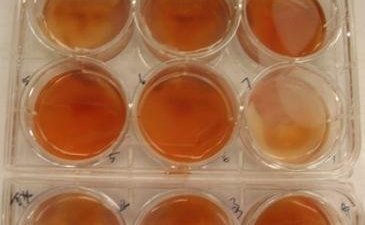

Scientist reported the misuse of infectious agents, OSU ruined his life and career

Scientist reported the misuse of infectious agents, OSU ruined his life and career
The Issue
My name is Mahesh Khatri and I worked as a Research Scientist in The Ohio State University’s Food Animal Health Research Program (FAHRP) in Wooster, OH. In 2011, I reported the misuse of dangerous infectious agents regulated under the Agricultural Bioterrorism Protection Act of 2002 and 9 CFR 121 (H5N1 highly pathogenic influenza virus and Texas GB Newcastle disease virus (NDV) in Dr. Chang-Won Lee’s lab in FAHRP. Due to this whistle blower activity and due to a chronic medical condition of my son (he suffers from ‘Adrenal Insufficiency’), I was held hostage and subjected to continuous harassment, exploitation and retaliation.
Soon after I joined FAHRP in September, 2008, Dr Lee took advantage of the fact that I absolutely needed a job that provided medical insurance due to the medical condition of my son. Dr. Lee took my novel grant/idea and submitted it under his name. He also wanted to take my research which I had done while I was in University of Minnesota and was trying to force me to give him a cell line developed by me which he wanted to send to outside researchers without following University rules. Dr. Lee blocked my job applications to other schools and would often threaten me. I had to comply with his wishes because I needed a job and medical insurance to keep my son alive. I reluctantly wrote a research grant for Dr. Lee, when he told me that he needs a grant for his promotion and he has problems in writing and has heart related issues.
I went to the Department Head, Dr. Yehia Mohamed (Mo) Saif, on several occasions requesting to no longer work with Dr. Lee. At that time Dr. Lee was hosting several students and visiting scholars from Dr. Saif’s home country of Egypt, so he able to easily convince Dr. Saif not to move me out of his lab. After obtaining a research grant, I paid my salary from my grant and moved out of Dr. Lee’s lab with the hope that now my job applications will not be blocked. Dr. Mo Saif also used my son’s need for medical insurance against me and forced me to write his student’s, Abdul Rauf, PhD thesis. Abdul was not able to do even elementary school calculations, but he did Dr. Saif’s personal tasks at work and at Dr. Saif’s home.
I taught Dr. Lee and his lab members basic virological and immunological concepts and watched in disbelief while these people misused dangerous infectious agents in the lab, which was not equipped to handle such agents. As these infectious agents posed a danger to human and animal lives, I decided to report this serious violation and was subjected to continued retaliation from throughout the department and the campus administration. Dr. Jeff LeJeune, who was promoted as the next FAHRP Department Head in February 2013, also blocked my job applications, used money from my federally-funded research grants, and threatened that he would destroy my career and give me so much stress that my adrenal glands will stop functioning. Dr. Linda Saif, who is Dr. Mo Saif’s wife and Professor in the department and member of National Academy of Sciences, threatened that she had provided negative reviews for me in the past and will not let me get a faculty position in the department or in any Veterinary/Animal Sciences School in the United States. When I approached administration, including Director David Benfield, who in the 1990s used to work in Dr. Linda Saif’s lab, and Elayne Siegfried, HR Director, for help to stop retaliation and provided them with the evidence, names of the witnesses, and documentation of misuse of dangerous infectious agents and misuse of my grant money, they forced me to undergo a ‘Fitness for Duty’ Psychiatric examination. Retaliation continued when I returned to work after passing the Fitness exam. Acting Department Head Dr. Gireesh Rajashekara, like previous heads, blocked my job applications and misused my grant money. He also retaliated against me because my wife had refused to work in his lab, as a few female workers in his lab whom we knew had quit his lab due to unpleasant working conditions. I also sent a request for help to the OSU President and other senior administrators at the main campus in Columbus. However, instead of any help, my employment was terminated in March 2018. As I had no other option and I have limited resources, I, myself, filed a complaint against the OSU in the Federal court for retaliation because of my whistleblower activity and perceived disability. The Ohio Attorney General’s Office is representing OSU in court. The fact that I reported a national security issue and that my son has a serious health condition, does not give OSU the right to exploit my situation and destroy my life and my career. I request my fellow citizens join me in asking OSU to stop the culture of discrimination and retaliation and I demand my research career back. I also plea that civil right activists and employment attorneys help me with the ongoing complaint in court.
120
The Issue
My name is Mahesh Khatri and I worked as a Research Scientist in The Ohio State University’s Food Animal Health Research Program (FAHRP) in Wooster, OH. In 2011, I reported the misuse of dangerous infectious agents regulated under the Agricultural Bioterrorism Protection Act of 2002 and 9 CFR 121 (H5N1 highly pathogenic influenza virus and Texas GB Newcastle disease virus (NDV) in Dr. Chang-Won Lee’s lab in FAHRP. Due to this whistle blower activity and due to a chronic medical condition of my son (he suffers from ‘Adrenal Insufficiency’), I was held hostage and subjected to continuous harassment, exploitation and retaliation.
Soon after I joined FAHRP in September, 2008, Dr Lee took advantage of the fact that I absolutely needed a job that provided medical insurance due to the medical condition of my son. Dr. Lee took my novel grant/idea and submitted it under his name. He also wanted to take my research which I had done while I was in University of Minnesota and was trying to force me to give him a cell line developed by me which he wanted to send to outside researchers without following University rules. Dr. Lee blocked my job applications to other schools and would often threaten me. I had to comply with his wishes because I needed a job and medical insurance to keep my son alive. I reluctantly wrote a research grant for Dr. Lee, when he told me that he needs a grant for his promotion and he has problems in writing and has heart related issues.
I went to the Department Head, Dr. Yehia Mohamed (Mo) Saif, on several occasions requesting to no longer work with Dr. Lee. At that time Dr. Lee was hosting several students and visiting scholars from Dr. Saif’s home country of Egypt, so he able to easily convince Dr. Saif not to move me out of his lab. After obtaining a research grant, I paid my salary from my grant and moved out of Dr. Lee’s lab with the hope that now my job applications will not be blocked. Dr. Mo Saif also used my son’s need for medical insurance against me and forced me to write his student’s, Abdul Rauf, PhD thesis. Abdul was not able to do even elementary school calculations, but he did Dr. Saif’s personal tasks at work and at Dr. Saif’s home.
I taught Dr. Lee and his lab members basic virological and immunological concepts and watched in disbelief while these people misused dangerous infectious agents in the lab, which was not equipped to handle such agents. As these infectious agents posed a danger to human and animal lives, I decided to report this serious violation and was subjected to continued retaliation from throughout the department and the campus administration. Dr. Jeff LeJeune, who was promoted as the next FAHRP Department Head in February 2013, also blocked my job applications, used money from my federally-funded research grants, and threatened that he would destroy my career and give me so much stress that my adrenal glands will stop functioning. Dr. Linda Saif, who is Dr. Mo Saif’s wife and Professor in the department and member of National Academy of Sciences, threatened that she had provided negative reviews for me in the past and will not let me get a faculty position in the department or in any Veterinary/Animal Sciences School in the United States. When I approached administration, including Director David Benfield, who in the 1990s used to work in Dr. Linda Saif’s lab, and Elayne Siegfried, HR Director, for help to stop retaliation and provided them with the evidence, names of the witnesses, and documentation of misuse of dangerous infectious agents and misuse of my grant money, they forced me to undergo a ‘Fitness for Duty’ Psychiatric examination. Retaliation continued when I returned to work after passing the Fitness exam. Acting Department Head Dr. Gireesh Rajashekara, like previous heads, blocked my job applications and misused my grant money. He also retaliated against me because my wife had refused to work in his lab, as a few female workers in his lab whom we knew had quit his lab due to unpleasant working conditions. I also sent a request for help to the OSU President and other senior administrators at the main campus in Columbus. However, instead of any help, my employment was terminated in March 2018. As I had no other option and I have limited resources, I, myself, filed a complaint against the OSU in the Federal court for retaliation because of my whistleblower activity and perceived disability. The Ohio Attorney General’s Office is representing OSU in court. The fact that I reported a national security issue and that my son has a serious health condition, does not give OSU the right to exploit my situation and destroy my life and my career. I request my fellow citizens join me in asking OSU to stop the culture of discrimination and retaliation and I demand my research career back. I also plea that civil right activists and employment attorneys help me with the ongoing complaint in court.
120
The Decision Makers
Petition Updates
Share this petition
Petition created on June 18, 2019